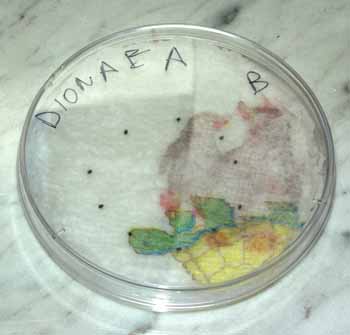
Reci&eacute;n salidas del frigorifico
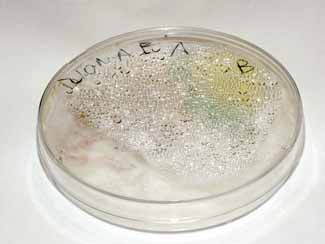
Manteniendo la humedad

|
 |
Dionaea muscipula : Venus Atrapamoscas / Diario - Cronología Fotográfica
Índice del Diario :
(1) Aclimatación
(2) Desarrollo del tallo floral
(3) Floración
(4) Alimentación
(5) Polinización
(6) Obtención de semillas
(7) Germinación
de semillas
(8) Estratificación fría
Diario - Cronología Fotográfica :
8. Estratificación fría
El proceso de estratificación fría de Dionaea muscipula se basa en cuatro fases qeu deben realizarse de forma consecutiva :
Fase 1 : Sembrar sobre superficie húmeda de medio, dejándolo entre 1 y 3 días a una temperatura de 20ºC
Fase 2 : Situar en refrigerador a una temperatura entre 0ºC y 5ºC durante 6 u 8 semanas, controlar el moho aplicando un fungicida a las semillas en unas proporciones no muy altas (en mi caso no fue necesario)
Fase 3 : Situar en lugar luminoso con una temperatura entre 15ºC y 25ºC y un 100% de humedad durante varias semanas hasta que germinen las semillas
Fase 4 : Trasplantar cuando la planta se haya despojado de la semilla y hayan aparecido las hojas auténticas (las dos primeras son los cotiledones).
Día : 26/06/2004
Tiempo de cultivo : 139 días
Estado : Después de haber dejado las semillas en el frigorífico 7 semanas saco las semillas y las sitúo en lugar bien iluminado para ver el porcentaje de geminación.
Con las semillas frescas el resultado fue muy pobre: sólo germinó 1 de 7, es decir un 14,25%. Ya sé que con muestras tan pequeñas los porcentajes no son fiables, no obstante este resultado encaja perfectamente con el porcentaje esperable cuando se utilizan semillas frescas.
Espero que estas siete semanas de frigorífico hayan "convencido" a estas diez semillas del Grupo B de que ya ha pasado todo el invierno y de que ha llegado el momento de germinar.
Fotos :
Día : 03/07/2004
Tiempo de cultivo : 146 días
Estado : La habilidad cazadora de la Dionaea muscipula es impresionante. No hay mosca que pase cerca que se sienta atraída y, en muchísimos casos, el fin de la mosca es terminar encerrada en la trampa, que se cierra vertiginosamente en el momento más oportuno.
Fotos :
 |
 |
 |
Día : 04/07/2004
Tiempo de cultivo : 147 días
Estado : Cada Dionaea muscipula puede adoptar indistintamente el papel de "planta madre" o "planta padre".
Es decir: Cualquiera de las flores de una planta tiene una parte masculina, también llamada estambres, y una parte femenina, denominada pistilo.
Por lo tanto la Dionaea muscipula puede llegar incluso a auto-polinizarse (autogamia), siendo la misma planta "madre" y "padre" a la vez.
No obstante, siempre es preferible realizar el proceso de polinización cruzando entre dos plantas distintas. Este proceso cruzado puede ser doble, es decir cada planta será a la vez "madre" y "padre".
En cualquier caso, yo preferí utilizar una de las plantas como donante de polen, a la que llamo "planta padre", y otra como receptora de polen, a la llamo "planta madre". Pero ni siquiera puedo asegurar que el proceso de germinación fuera en el sentido en que yo lo intenté.
Como se puede apreciar en estas dos fotos, las plantas padre y madre están ambas muy aceptables, especialmente la planta padre que era muy pequeña y debilucha y ahora crece vigorosamente.
Fotos :

Día : 04/07/2004
Tiempo de cultivo : 147 días
Estado : Sólo ocho días después de haber sacado las semillas del frigorífico ya ha germinado la primera semillas.
Aún no puedo asegurar que la estratificación fría mejore el porcentaje de germinación, pero desde luego lo que si ha disminuido sensiblemente es el tiempo necesario para que germine la primera semilla. ¡Espero que no sea la única!.
Fotos :

Día : desde el 04/07/2004 hasta el 25/07/2004
Tiempo de cultivo : 168 días
Estado : Durante las tres semanas siguientes a la germinación de la primera semilla, se produjo un lento pero continuo proceso de crecimiento en la placa petri. Durante todo este tiempo me aseguré de que la base estuviera siempre mojada y de que hubiera un altísimo nivel de humedad dentro de la placa.
Como en mi anterior intento cuando realicé el trasplanta desde la placa petri a medio de cultivo definitivo se produjo un rápido proceso de secado y muere de la planta, en esta ocasión decidí esperar, al menos, tres semanas antes de realizar el trasplante.
El cuarto día después de haber germinado la planta había crecido lo suficiente como para que se pudieran apreciar perfectamente los dos cotiledones.
El noveno día se produjo la separación de los dos cotiledones y ya se apreciaba perfectamente la primera hoja verdadera creciendo en medio de los dos cotiledones.
El día decimoprimero la planta se liberó de forma autónoma de la semilla. Además del continuo crecimiento de la hoja se apreciaba también un crecimiento en la raíz de la nueva planta.
El día decimocuarto la primera hoja había crecido mucho (relativamente) y ya se apreciaba la forma típica de las hojas de Dionaea.
El día decimosexto la primera hoja continuaba creciendo y ya se apreciaba una incipiente segunda hoja.
El día decimoctavo la primera hoja tenía incluso una mini-trampa (el tamaño de la planta es realmente pequeño) perfectamente formada.
El día vigésimo primero la segunda hoja empezaba a tomar una posición vertical y decidí que había llagado el momento de trasplantar. ¡Espero que esta vez tenga mejor suerte en la ocasión anterior!
Fotos :
|
04/07/2004 |
05/07/2004 |
06/07/2004 |
07/07/2004 |
|
11/07/2004 |
12/07/2004 |
13/07/2004 |
14/07/2004 |
|
15/07/2004 |
17/07/2004 |
19/07/2004 |
21/07/2004 |
|
22/07/2004 |
24/07/2004 |
25/07/2004 |
Día : 11/07/2004
Tiempo de cultivo : 154 días
Estado : Como en el caso anterior la nueva planta terminó secándose, en esta ocasión estoy manteniendo un alto nivel de humedad en la placa donde estoy manteniendo a la Dionaea antes de trasplantarla al medio definitivo de cultivo.
Fotos :
Dentro del Grupo B (el que fue sometido a la estratificación fría) ha germinado una segunda semilla. Estoy a la expectativa porque parece que, en efecto, el paso por el frigorífico hará que los resultado sean mejores.

Día : 12/07/2004
Tiempo de cultivo : 155 días
Estado : Tengo la sensación de que esta vez la cosa va mejor que en el caso anterior y decido comparar fotos de las nueva planta en el mismo momento del proceso de germinación para ver si hay diferencias y, ¡en efecto! En este caso la planta está desarrollando raíz mientras que en el caso anterior, aunque estaba creciendo una hoja autentica, la raíz no se desarrollaba.
Cabe suponer que el fracaso del caso 1 se debió a está falta de raíz y no, como supuse en su momento, a que hiciera demasiado calor o que tuviera poca humedad.
Si esta suposición es correcta imagino en este segundo caso tendré más probabilidades de éxito.
Fotos :
|
CASO 1 : Estado de la planta que murió |
CASO 2 : Estado de la planta en este |
Día : 12/07/2004
Tiempo de cultivo : 155 días
Estado : Como la planta ya se ha desprendido de la semilla está viviendo en un medio inerte en el que no tiene ningún tipo de alimento y, aunque sé que la Dionaea puede vivir en suelos muy pobres me da miedo mantenerla tanto tiempo sin ningún tipo de alimento.
Por eso decido que, durante la tercera semana que la mantendré en la placa petri en lugar de utilizar agua destilada para mantener húmedo el medio emplearé agua destilada ligeramente enriquecida con un fertilizante orgánico.
Finalmente empleo Bio Gold que es un abono muy suave y, además, hago una dilución mucho más ligera de los que recomienda el suministrador del abono. Para ello diluyo un solo grano de Bio Gold en un pequeño vaso de agua destilada durante sólo dos horas y media. Finalmente lo filtro para evitar que pase el abono sólido.
A partir de hoy, hasta que trasplante la planta al sustrato definitivo, este será el liquido que emplearé para mantener la base de papel siempre húmeda. Supongo que todo esto, en realidad, no será necesario, pero una mezcla tan suave no creo que pueda dañar a la plata.
 |
 |
 |
 |

Día : 24/07/2004
Tiempo de cultivo : 167 días
Estado : Dos semanas después de haber germinado la segunda semilla del Grupo B su crecimiento está completamente detenido por lo que supongo que, debido a alguna cosa que desconozco, esta segunda semilla no será viable.
Si damos por finalizado el proceso de germinación de este segundo grupo de semillas al que se sometió a la estratificación fría, el porcentaje de geminaciones ha sido de un 20%, muy inferior a lo que esperaba.
En realidad, el porcentaje de éxito es casi el mismo que se obtuvo con la semillas que no pasaron por la estratificación fría, que fue del 14,29%. Con una muestra tan pequeña, en este caso, lo único que se puede decir es que el porcentaje de germinaciones obtenido ha sido muy similar utilizando el proceso de estratificación fría que sin utilizarlo.
Fotos :

En cuanto a la planta que germinó el pasado día 4, doy por terminado el proceso de germinación, ahora espero que el fuerte calor que tenemos en Madrid no me dificulte demasiado el cultivo de la misma.
Para mantener la humedad voy a utilizar una tapa trasparente para la maceta donde la he trasplantado.

Día : 31/07/2004
Tiempo de cultivo : 174 días
Estado : Todo va bien.
La nueva planta ha sido trasplantada al medio de cultivo definitivo y mantiene muy buen aspecto. La pequeña trampa, aunque en la fotografía se vea algo desenfocada, mantiene un excelente aspecto y, aunque es muy pequeña, está perfectamente formada.
Fotos :

Día : 10/08/2004
Tiempo de cultivo : 184 días
Estado : El ritmo de crecimiento es muy lento, pero la nueva planta continúa saludable. Mantiene perfectamente la hoja que tenía y ya se aprecian lo brotes de nueva hojas.
Parece que esta vez la planta sobrevivirá.
Fotos :

Día : 20/08/2004
Tiempo de cultivo : 194 días
Estado : ¡Pues no!.
He estado cinco días fuera de casa y dejé la pequeña Dionaea con mucho agua en el plato, si embargo, al regresar el sustrato estaba completamente seco y, ¡lo que es peor!, también estaba completamente seca la planta.
Agosto es un mes muy caluroso y seco en Madrid y me temo que el agua no ha sido suficiente como para mantener húmedo el sustrato durante los cinco días.
He vuelto a regar la tierra, pero sé que la planta está definitivamente muerta. Es una lastima porqué esta vez todo estaba funcionando correctamente. ¡Que le vamos a hacer!
Fotos :

















